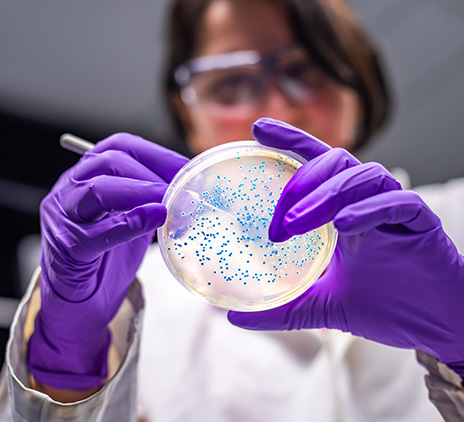

Vi gennemgår reglerne omkring gratis opladning af elbiler for medarbejdere, kunder, leverandører og samarbejdspartnere.
Vi gennemgår reglerne for moms ved handel med virksomheder inden for EU.
Grant Thornton fik 22. april InterForce-skjoldet, som blev overrakt til Bestyrelsesformand i Grant Thornton, Michael Winther Rasmussen.
Vi gennemgår kørselsfradraget, hvilke betingelser, du skal opfylde for at få det, samt satserne for kørselsfradrag i 2024 og 2023.
Vi gennemgår fristerne for betaling af A-skat og AM-bidrag i 2024 for både små/mellemstore og store virksomheder.
Vi gennemgår skattereglerne for personer, som har bopæl i Danmark og udfører lønarbejde i udlandet.
Vi gennemgår, hvad en Skattekonto er, og hvordan du bruger Skattekontoen i din virksomhed.
Vi gennemgår, hvordan SKAT vurderer, om en virksomhed med vedvarende underskud er erhvervsmæssig eller en hobbyvirksomhed.
Vi gennemgår de skattemæssige forhold, der gør sig gældende for personalegoder i 2024.
Vi gennemgår, hvad en whistleblowerordning er, hvad ordningens formål er, og hvem der er omfattet af whistleblowerloven.
Vi gennemgår det forhøjede fradrag for forsøgs- og forskningsvirksomheder i 2024.
Vi gennemgår, hvad acontoskat er, hvilke virksomheder der skal betale det, og hvornår på året man skal betale acontoskat.
Vi gennemgår, hvad seniorpræmie er, og hvilke betingelser du skal opfylde for at have ret til skattefri seniorpræmie.
Vi gennemgår reglerne for fradrag for donationer til foreninger, og hvordan din virksomhed kan få fradrag for donationer.
Vi gennemgår personligt ejede virksomheder og selskaber, så du kan danne dig et overblik over de forskellige virksomhedsformer.
Vi gennemgår, hvad restskat kan skyldes, og hvad du skal være opmærksom på for at slippe for at betale restskat næste år.